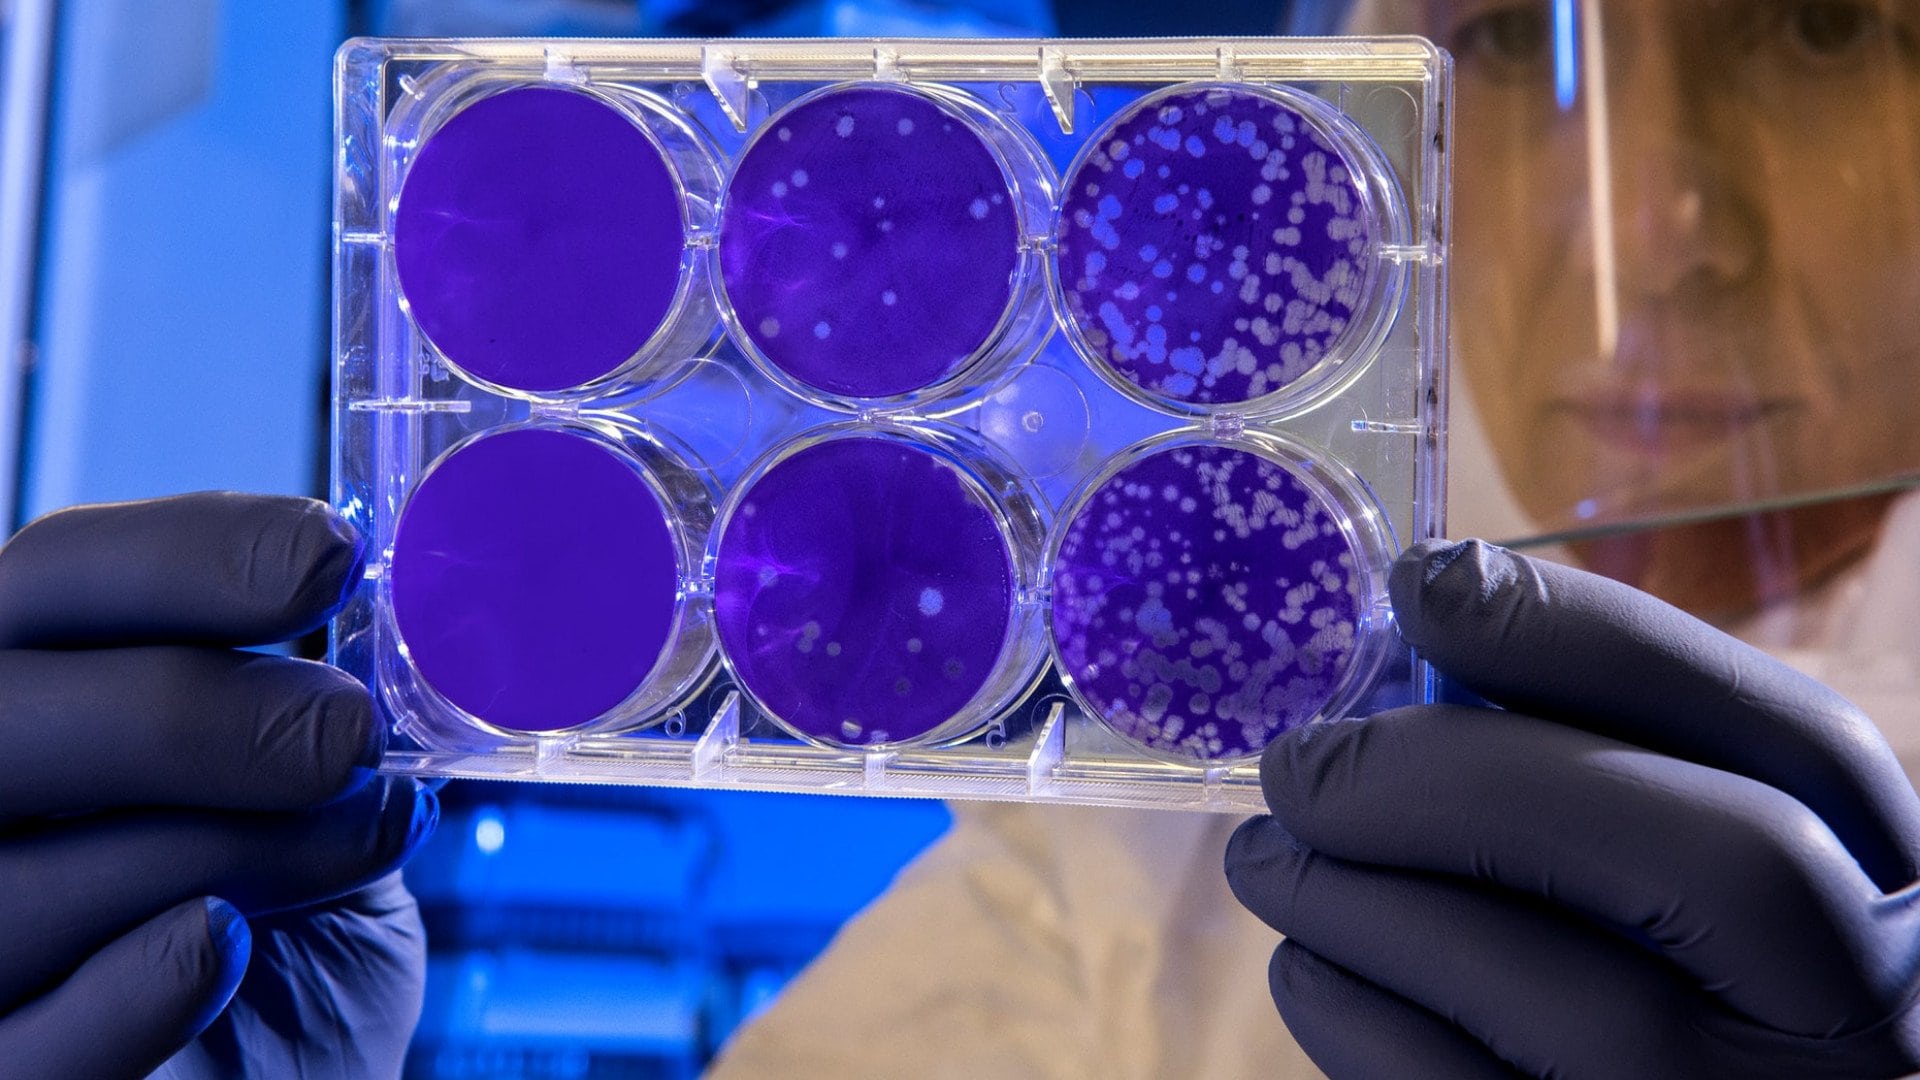

Predveď svoje všeobecné vedomosti: Tento kvíz zvládnu len skutoční géniovia
- Prevetraj svoje všeobecné vedomosti v našom kvíze
- Zvládnu ho len ozajstní géniovia

Niekto zvláda otázky z humanitných vied, niekto má radšej matematiku či fyziku. Ukáž, ako si poradíš v kvíze zo všeobecných vedomostí. Nebudeš to mať vôbec ľahké, kvíz pozostáva z histórie, chémie, biológie či umenia.
Predveď svoje všeobecné vedomosti v našom obzvlášť ťažkom kvíze, plný počet dosiahnu iba naozajstní géniovia. Trúfneš si?
Calcium je latinský názov chemického prvku:
 Unsplash/ Vedrana Filipović
Unsplash/ Vedrana Filipović
Calcium (Ca) je latinský názov vápnika.
Thomas Edison sa považuje za vynálezcu:
 Wikimedia/Louis Bachrach
Wikimedia/Louis Bachrach
Thomas Alva Edison sa považuje za vynálezcu žiarovky. V skutočnosti ale v tom istom období pracovali na rovnakom vynáleze aj mnohí iní vedci, napríklad Joseph Wilson Swan. Edison bol ale prvý, kto si dal vynález patentovať.
Tretia vojna v Perzskom zálive sa začala v roku:
 U.S. Army/Cory Grogan
U.S. Army/Cory Grogan
Tretia vojna v Perzskom zálive, tiež známa ako vojna v Iraku, sa začala v roku 2003. Viedli ju Spojené štáty a Veľká Británia, oficiálne sa stala ďalšou oblasťou vojny proti terorizmu. Pred vojnou sa množili podozrenia, že režim Saddáma Husajna vlastní zbrane hromadného ničenia. Po invázii do Iraku sa však žiadne zbrane nenašli.
Kde bol súdený a popravený zbojník Juraj Jánošik?
 Wikimedia/Jirka23
Wikimedia/Jirka23
Juraj Jánošík bol súdený a popravený v Liptovskom Mikuláši, pravdepodobne v okolí dnešného Múzea Janka Kráľa. Miesto jeho popravy nie je presne známe, predpokladá sa však, že išlo o územie medzi dnešnými mestskými časťami Okoličné a Vrbica.
Kulajda je polievka, ktorá pochádza z:
 Wikimedia/Radek Schenk
Wikimedia/Radek Schenk
Kulajda je polievka z južných Čiech, ktorá sa považuje za tradičnú českú polievku a jedno z národných jedál. Pozostáva zo zemiakov, kôpru, hríbov, smotany a vajca.
Hlavným mestom Monaka je:
 Freepik/frimufilms
Freepik/frimufilms
Hlavným mestom Monaka je mesto s rovnakým názvom, a teda Monako.
Kamala Harrisová bola pred nástupom do funkcie viceprezidentky senátorkou za štát:
 SITA/AP, John Raoux
SITA/AP, John Raoux
Kamala Harrisová bola pred nástupom do viceprezidentského kresla senátorkou za štát Kalifornia.
Cher nie je autorkou piesne:
 Wikimedia/Raph_PH
Wikimedia/Raph_PH
Autorkou piesne Material Girl je Madonna.
Slováci sa stali majstrami sveta v hokeji v roku:
 TASR
TASR
Slováci sa stali majstrami sveta v roku 2002 vo Švédsku, kde zdolali Rusko.
Tento obraz namaľovala?
 Wikimedia
Wikimedia
Obraz je dielom mexickej maliarky Frida Kahlo. Dielo ma viaceré interpretácie, niektorí tvrdia, že má zobrazovať jej trápenie po nevydarenej operácii, ďalší tvrdia, že môže zobrazovať jej neschopnosť kontrolovať svoj vlastný osud.
Ktoré z nasledujúcich ochorení sú spôsobené iba baktériami?
Unsplash/@cdc
Unsplash/@cdc
Chrípka, HIV, koronavírus a besnota sú choroby spôsobené vírusmi.
Kde bola Mária Terézia korunovaná za uhorskú kráľovnú?
 Wikimedia
Wikimedia
Za uhorskú kráľovnú bola Mária Terézia korunovaná v Dóme sv. Martina v Bratislave.
Ako dlho trvá Chanuka?
 Unsplash/Diana Polekhina
Unsplash/Diana Polekhina
Jeden z najväčších židovských sviatkov trvá osem dní. Tento židovský sviatok sa každoročne oslavuje na prelome novembra a decembra. Prostredníctvom neho si židia pripomínajú posvätenie jeruzalemského chrámu, ktoré sa uskutočnilo v 2. storočí pred naším letopočtom.
Aký je chemický vzorec vody?
 Unsplash/@nutnp
Unsplash/@nutnp
Voda alebo aqua má chemický vzorec H2O, podľa tradičného názvu oxid vodný, novší systémový názov oxidán. Ide o chemickú zlúčeninu vodíka a kyslíka. Je základnou podmienkou pre existenciu života na Zemi. Za normálnej teploty a tlaku je to bezfarebná, číra kvapalina bez zápachu a chuti.
Gréckym slovom kosmos označujeme:
 Unsplash/Vincentiu Solomon
Unsplash/Vincentiu Solomon
Gréckym slovom kosmos sa označuje vesmír.
Čítaj viac z kategórie: Kvízy










